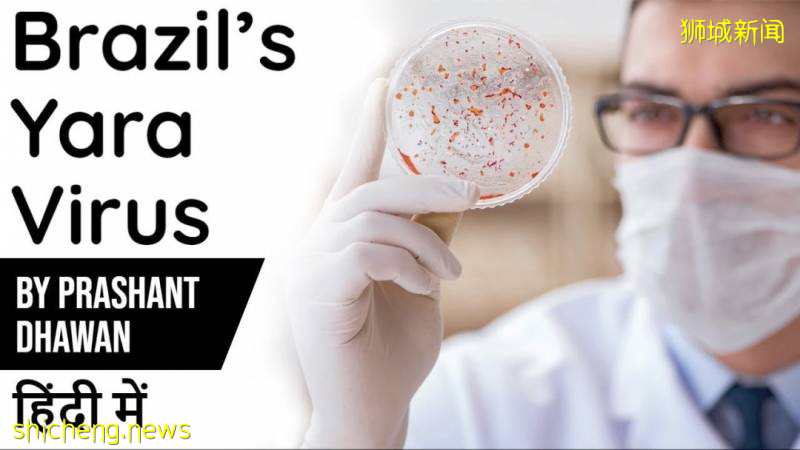
全球確診破700萬!2020,見證曆史的一年!

2020年注定是不平凡的一年
轉眼間,半年過去
我們已經經曆了太多的第一次
看見太多的不平凡
也見證著很多從未發生過的曆史
全世界大事件,接連不斷發生
不斷沖擊著我們的生活
新冠肺炎在全球肆虐
讓人更懂得眼前的寶貴
全球經濟的下行
油價跌破負值
各國爲經濟複蘇出台多項舉措
無論怎樣,好的壞的,又過去半年, 讓我們共同回顧一下吧~
盤點2020年上半年全球大事
澳大利亞林火
從2019年9月起
大火持續燒了四個多月
煙霧蔓延到12000公裏外的南美洲
來源:Getty images
大火的覆蓋範圍之大
相當于91個紐約
將近5億只動物遭受大火威脅
超2萬只考拉變“烤啦”
澳洲民衆,深受其害
只能眼睜睜地,看著家園被毀
1月3日
美軍刺殺伊朗將軍
伊朗最高將領蘇萊曼尼
在伊拉克巴格達國際機場外
遭美軍無人機精准導彈襲擊身亡
1月8日
烏克蘭客機遭伊朗導彈擊落
一架載有176人的烏克蘭客機
在伊朗德黑蘭機場附近
起飛後就墜毀,機毀人亡
成爲震驚全球的伊朗空難慘案
圖源:人民日報
圖源:BBC
1月12日
菲律賓塔阿爾火山爆發
爆發式噴發
火山灰高達10至15公裏
火山爆發地
距離首都馬尼拉僅約60公裏
火山灰侵襲城市
1萬多居民緊急撤離
航班受嚴重影響
1月14日
克什米爾雪崩
巴基斯坦地區多次發生雪崩
至少76人死亡,多人失蹤
超過50棟房屋被埋
鄰國印度也至少有10人遇難
1月17日
非洲25年來最嚴重蝗災
東非持續爆發遮天蔽日的蝗災
25年來最嚴重
政府啓動軍用機對抗
蝗蟲在沙漠中棲息繁殖後代,
後在4月再次爆發
千億蝗蟲從非洲蔓延至中東地區
直抵南亞進入印巴,逼近中國
1月18日
加拿大暴雪封城
當地30年以來最大暴雪
伴隨時速130公裏的狂風
讓城市交通陷入癱瘓
僅僅兩小時在室內閑聊的居民
起身後發現房屋已被厚重的雪牆困住
1月19日
新型肺炎疫情全面爆發
從1月開始的新型冠狀肺炎COVID-19
疫情肆虐,開始在全世界傳播
令人擔憂的是,其病情源頭還尚未知
截止到6月7日
來自worldometers的數據
全球確診病例爲6,974,721人
死亡人數爲402,094人
圖源:worldometers
迄今爲止,
世界各國在疫苗研發上投入巨大
但疫苗依然沒有面市
圖源:Reuters
我們只能繼續期盼,
繼續戴口罩,保持安全距離
期待疫苗早日成功!
1月21日
西班牙遭遇強風暴
風暴造成至少10人死亡
4人失蹤、數10人受傷
超過20萬人的電力被中斷
來源:rpp
1月23日
美國爆發40年來最致命乙型流感
美國爆發40年來最致命流感
從2019年10月至2020年1月
逾1900萬人受感染,約18萬人住院
流感蔓延範圍,全美飄紅
1月26日
印度尼西亞洪水
首都雅加達及其周邊地區
發生強降雨,
導致周邊許多地區遭受洪水襲擊
來源:THE NEW YORK TIMES
暴雨造成21人喪生,
2萬名居民疏散到臨時避難所
1月27日
阿富汗航班墜毀
阿富汗阿裏亞納航空公司一架飛機
墜毀在東部塔利班控制區域
機上83人死傷不明
1月27日
籃球巨星科比飛機失事
科比,科比!
一代巨星,隕落!
科比與二女兒乘坐的私人飛機
在加州洛杉矶山區墜毀
父女二人均在這場空難中喪生
引起全世界球迷及網友的哀悼
1月29日
古巴發生7.7級地震
1月29日
丹麥爆發禽流感
丹麥北部發生H5N1低致病性禽流感疫情
疫情源頭尚屬未知
多達48,000只禽類受影響
來源:on.cn
2020年1月31日
英國脫歐
讓非歐元區的英國受到嚴重牽連
在2016年舉行脫歐公投
2020年1月正式脫歐
來源:BBC
僅剛年初就事件不斷
注定今年就是困難模式了!
是不是已經覺得很多了?
其實並不然,才只是過去一月份
接下來繼續看二月份~
2020年2月3日
70萬只蝙蝠入侵澳大利亞
數月的澳大利亞山火
逼出65萬只毒王——蝙蝠
這些蝙蝠占據城市的上空
嚴重影響到人類的正常生活
來源:PHILNEWS
據稱蝙蝠當中還有吸血蝙蝠、狗頭蝙蝠
身上攜帶了大量的細菌和病毒
對人類造成嚴重的威脅
2020年2月9日
尼日利亞爆發不明疾病
尼日利亞發現了不明病毒
這個病毒目前已經席卷19個州,
造成47人死亡,365人感染,
患者發病後48小時內死亡。
同時,尼日利亞又爆發了
新一輪的拉沙熱疫情
圖源:Al Jazeera
病情蔓延26個州,發現1708例疑似病例,
472例已確診,70人死亡,病死率爲14.8%
2020年2月11日
巴西發現神秘病毒
在巴西的人工湖Lake Pampulha中
發現了一種神秘病毒Yaravirus
來源:YOUTUBE
這種病毒的90%基因根本無法識別
與目前已知的8500公開的宏基因組的搜索對比
僅僅和6個Yaravirus有親緣關系
2020年2月15日
南極有史以來首次突破攝氏20度高溫
巴西科學家在南極測得攝氏20.75度的新高溫記錄
這是有記錄以來
南極首次超過攝氏20度
全球變暖,
意味者動物的棲息地縮小
圖源:HITC
更多的冰川融化
導致埋藏在南極凍土層的
像天花病毒一樣的28種各種病毒
將再來襲地球
2020年2月15日
馬來西亞仙本那突發大火
曾經的仙本那,作爲世界的旅遊中心,
明明美得令人窒息
然而,這一場大火突襲
燒毀房屋30間
萬幸的是,這裏距離鎮中心較遠
並未影響相關的旅遊度假區
2020年2月15日
英國多處地區遭到洪水預警
英國在兩周內
經曆了兩次台風級別暴風
多處地區發出洪水預警
圖源:BBC News
造成數百個房屋被洪水淹沒
超過500,000的房屋沒有電力
導致航班與火車服務被取消
道路被封閉,學校關閉
圖源: BBC News
在第一次風暴Ciara中
一名男子因被倒下的樹撞擊而去世
圖源:The Guardian
大自然的威力
永遠都只能讓人望而生畏
長噓一口氣,先短暫休息下
2月也是不平凡的月份
繼續來看3月的吧~
2020年3月
阿富汗戰爭停戰又爆發
2月29日,美國和塔利班簽署“全面和平協議”
美方同意在14個月內從阿富汗撤出全部部隊
原本以爲曠達19年之久的戰爭終于結束
然而……
一覺醒來,中東又變天
美軍停戰協議被撕毀
塔利班揚言,再打20年
毫無契約精神,難道是小孩子打架嗎?
2020.3.11
世界衛生組織宣布
冠狀病毒COVID-19大流行
截止當日
全球範圍內共有121,564例病例
死亡4,373例
數據還在不斷攀升
4月5日
英國首相鮑裏斯·詹森
因感染新冠入院
由于感染冠狀病毒,
英國首相鮑裏斯·詹森(Boris Johnson)
病情加重,住進醫院
圖源:Getty
4月7日
新加坡史上首次進入阻斷期
停工停學,全民宅家
酒吧,KTV,電影院關閉
商場基本關門,除了餐廳可以打包
圖源:總理辦公室
4月20日
美國石油價格曆史上首次出現負數
因爲新冠流行,全球需求下降,
原油價格跌至每桶負37.63美元,
這是曆史上首次出現負數
圖源:新華網
昔日忙碌的石油井地
現在空無一人
只有牛羊們在孤獨的陪伴
讓人不禁唏噓不已
5月7日
英國經濟正走向300年來最嚴重的崩潰
疫情影響著全世界經濟
英國經濟最壞結果也出現了!
根據英國央行預測,
英國經濟可能陷入,自1706年以來
300年最嚴重的衰退
圖源:CNN
2020年第二季度,英國GDP同比可能暴跌35%
失業率升至10%
英國預算責任辦公室指出
將比任何一次世界大戰或金融危機都要糟糕
5月19日
研究報告全球溫室氣體排放量下降了17%
疫情影響,人類都宅在家
動物們開始恢複走向自然
從《自然氣候變化》的研究報告中得知
全球溫室氣體排放量下降了17%
圖源:Getty
由于全球人類活動減少,
天空變得更藍了
也許這次疫情,留給我們更多思考
我們到底應該如何保護好地球
青山綠水
才是人類與動物們共同的樂園
5月25日起
全球各地爆發示威遊行與暴動
一名警察將黑人男子弗洛伊德反扣在地上
用膝蓋將其脖子死死壓住7分鍾
該男子因窒息死亡
從視頻中看出,弗洛伊德並未反抗
只是一邊痛苦地呻吟一邊向警察求饒:
“我要窒息了,讓我喘口氣吧。”
來源:紐約時報
引發了廣泛的譴責和全國性抗議
快速演變爲暴動
並蔓延全美至少20個州,乃至全世界
紐約街頭暴亂,來源:彭博
加拿大街頭遊行示威,來源:Complex
英國倫敦街頭遊行示威,來源:Complex
澳洲街頭遊行示威,來源:CNN
6月2日
剛果爆發新一輪埃博拉疫情!
剛果新的埃博拉疫情爆發,
又是來勢洶洶,死傷生命無數
截止到5月25日的數據
疫情確診3406人,死亡2243人
死亡率平均爲50%
看到這數據,好怕怕啊~ 瑟瑟發抖
來源:NYT
6月3日
美國宣布暫停所有中國民航航班
中美航班之間的矛盾,
從疫情開始不斷變化
6月3日,美國交通部發表
美國特朗普政府擬從6月16日開始
暫停所有中國民航航班飛往美國
圖源:美國交通部
瞬間,這一禁令的出台
在美期盼回國的華人們
經曆過天價機票、輾轉改簽的重重磨難
無疑是雪上加霜
圖源:路透社
還好兩天後的6月5日,美方又宣布
更改此前針對中國航司的“斷航”令
允許部分中國民航客機繼續執飛美國
我想說,
這是朝令夕改嗎?
6月4日
新加坡環境局:史上最嚴重登革熱疫情
據衛生部統計,
今年1月到4月期間
每周增加的骨痛熱症病例從
300例上升到400例左右。
到5月的最後一周
病例更是激增到單周735起。
可以說自2013年和2014年這兩個高峰年份以後
新加坡的骨痛熱症每周病例數就沒這麽高過!
6月6日
新加坡副總理:有超10萬人失業
新加坡的就業市場也將因爲新冠疫情受到前所未有的沖擊。
副總理兼財政部長王瑞傑在昨天表示,初步預估本地2020年居民失業人數可能會超過10萬。
同時也會成爲自2003年非典疫情爆發以來的新高,當時非典導致的失業率是4.8%。
來源:yahoo | the indian express
看完了世界這半年的大盤點,
你是否跟我一樣,不斷感歎
全世界還有這麽多地方
因爲各種自然災害與沖突
這讓我們深感
在新加坡,安全感多麽的可貴
讓我們用一張表格也來看看
新加坡的這半年吧~
如果現在你的面前擺放一個按鈕,按下的話能夠讓2020年重新來過,你會按麽
我相信,很多小夥伴可能會去按那個按鈕。
如果,新的2020年真的重新來過,你會有什麽願望?
來源:https://www.shicheng.news